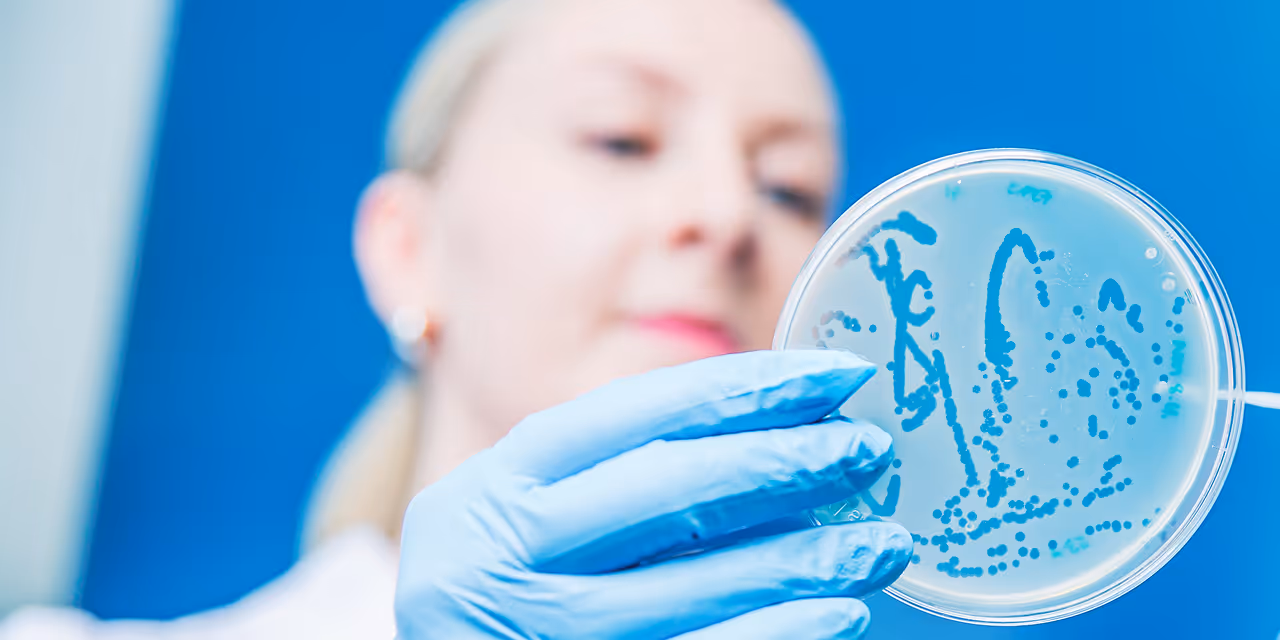
bacteriophage isolation and characterizaation

PrecisionPhage lab can help you with...
Phage sourcing & isolation
Custom phages, isolated from natural reservoirs for your specific needs.
Host range & susceptibility testing
Research-grade testing to determine the activity of phages against specific bacterial strains.
Phages handling & formulation
Research-grade phage handling and formulation to provide stable stocks for laboratory studies.
Genomic characterization
Along with laboratory work, we have strong capabilities of providing detailed genomic analysis for efficient subsequent work phases.
The easiest way to find a new phage
When your project requires a bacteriophage that is not already available in our existing collection, our phage isolation service provides a direct path to finding the right match. We source samples, screen them against your target strain, and isolate candidate phages with precision and care. On-demand BSL 3 capabilities.
When your project requires a bacteriophage that is not already available in our existing collection, our phage isolation service provides a direct path to finding the right match. We source samples, screen them against your target strain, and isolate candidate phages with precision and care. On-demand BSL 3 capabilities.

Modern phage laboratory
At PrecisionPhage, we pride ourselves on groundbreaking research and innovative solutions that drive success in biotechnology. Our commitment to excellence has established us as a trusted partner in the industry.
Our phage laboratory is fully equipped for various phage projects, backed by rich academic expertise.
Phage laboratory services complemented by phage bioinformatics, offering a uniquely comprehensive range of solutions for industry needs.

FAQs
We specialise in the most common antibiotic-resistant bacterial strains, but are capable of sourcing phages outside this domain. While some bacteria are more challenging, our experience and combined methodologies allow us to work successfully with even the more difficult targets.
Yes. Phages identified and confirmed through isolation will be made available according to agreement.
Timelines vary depending on the bacterial strain and sample source. Typically, isolation and basic characterisation require a few weeks.
Get in Touch
We’re here to help with any questions you may have. You can also find our team members and their contact details on the Team page.